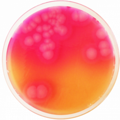
E-shop hlavní obrázek

Selenitový bujón se požívá na pomnožení a izolaci střevních patogenů rodu Salmonella a některých kmenů Shigella.

Selenitový bujón se požívá na pomnožení a izolaci střevních patogenů rodu Salmonella a některých kmenů Shigella.
Selektivní kultivační půda s mannitolem, vaječným žloutkem a polymixinem vyvinutá Mosselem je používaná pro enumeraci a izolaci Bacillus cereus ze vzorků potravin. Tento produkt je dodáván v dehydratované formě a je určen pro přípravu hotových kultivačních médií.

AESKULISA Serin-Prothrombin-A je enzymoimuno-analytická souprava pro kvantitativní a kvalitativní detekci IgA protilátek proti fosfatidylserinu a prothrombinu v lidském séru.

AESKULISA Serin-Prothrombin-GM je enzymoimuno-analytická souprava pro kvantitativní a kvalitativní detekci IgG a/nebo IgM protilátek proti fosfatidylserinu a prothrombinu v lidském séru.

AESKULISA Serin-Prothrombin-Check je enzymoimuno-analytická souprava pro kombinovanou kvantitativní a kvalitativní detekci IgG a IgM protilátek proti fosfatidylserinu a prothrombinu v lidském séru

Alergen určený na 4 stimulace standardizovaný a validovaný pro použití se soupravami CAST® ELISA a FLOW CAST®.

Souprava SHBG je imunoenzymatická metoda určená pro kvantitativní stanovení koncentrace SHBG v lidské plazmě nebo séru.

ELISA souprava je určená pro kvantitativní stanovení rozpustného HLA-G (sHLA-G) v plazmě, plodové vodě nebo supernatantu buněčných kultur.

Za určitých okolností mohou být anaerobní bakterie endogenní flóry a anaerobní bakterie z půdy transformovány na patogeny vyvolávající některé závažné infekce (infekce gynekologické, břišní, horních cest dýchacích, ústní dutiny, atd.). Schaedler agar s vit. K1 se používá k izolaci anaerobních bakterií.

Schaedler bujón je vhodný pro kultivaci anaerobních mikroorganismů.

Schadler bujón je vhodný pro kultivaci anaerobních mikroorganismů.

Schadler bujón je vhodný pro kultivaci anaerobních mikroorganismů.

Schaedler agar je selektivní půda, která se používá pro izolaci a kultivaci G- anaerobních mikroorganismů.

Schaedler agar selektivní pro G+ je částečně selektivní půda pro Gram pozitivní anaerobní bakterie výhodná zejména u vzorků, kde se dá očekávat smíšená flóra, protože dochází k inhibici růstu fakultativně anaerobních Gram negativních bakterií, zejména čeledi Enterobacteriacae. ( Gram negativní striktně anaerobní mikroorganizmy na půdě rostou, např. Bacteroides fragilis ).

Půda určená pro kultivaci anaerobních mikrorganismů z kontaminovaných vzorků. Tento produkt je dodáván v dehydratované formě a je určen pro přípravu hotových kultivačních médií.

Polotuhé médium pro diferenciaci střevních bakterií na základě produkce H2S, indolu a motility. Tento produkt je dodáván v dehydratované formě a je určen pro přípravu hotových kultivačních médií.

Simmons citrát agar je selektivní půda určená na diferenciaci enterobakterií na základě schopnosti využívat citrát.